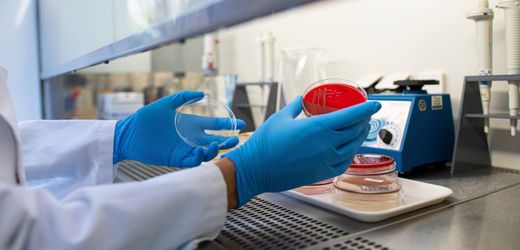

Ehec: Mecklenburg-Vorpommern meldet fünf weitere Fälle der gefährlichen Keime
Der Ehec-Ausbruch im Nordosten weitet sich aus, mittlerweile sind 22 Menschen betroffen. Keine Fortschritte gibt es bei der Suche nach der Infektionsquelle.
Der Ehec-Ausbruch im Nordosten weitet sich aus, mittlerweile sind 22 Menschen betroffen. Keine Fortschritte gibt es bei der Suche nach der Infektionsquelle. Weiterlesen